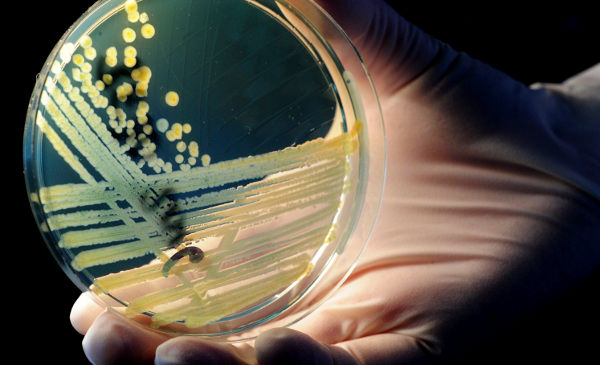

Los sustantivos superbacteria y supermicrobio se escriben en una sola palabra, sin espacio ni guion, y sin acento en el prefijo super-.
En los medios de comunicación es frecuente encontrar voces como superbacterias y supermicrobios escritas impropiamente, como en «Entramos en los criaderos de cerdos y peces donde, por atiborrarlos de antibióticos, nacen los súpermicrobios que amenazan al mundo», «La resistencia a los antibióticos es una amenaza cada vez mayor que puede permitir la aparición de super microbios», «Esta súper bacteria mortal se propaga fácilmente a través del contacto directo e indirecto» o «Una nueva arma para luchar contra las súperbacterias».
Según dispone la ortografía académica, el prefijo super- se escribe, como norma general, unido a la palabra a la que acompaña (sin espacio ni guion intermedio) y no lleva tilde. Por lo tanto, en los ejemplos anteriores, lo adecuado habría sido escribir «Entramos en los criaderos de cerdos y peces donde, por atiborrarlos de antibióticos, nacen los supermicrobios que amenazan al mundo», «La resistencia a los antibióticos es una amenaza cada vez mayor que puede permitir la aparición de supermicrobios», «Esta superbacteria mortal se propaga fácilmente a través del contacto directo e indirecto y «Una nueva arma para luchar contra las superbacterias».
Súper se escribe con tilde cuando se está empleando como sustantivo, esto es, cuando equivale a supermercado o designa un tipo de gasolina, o como adjetivo, como en gasolina súper; pero no cuando es un prefijo, como en supermicrobio, superbacteria, superhéroe, superestrella, etc.
Ver también
➤ super, escritura de este prefijo
➤ prefijos, seis claves para una buena redacción
➤ Turismofobia, noticias falsas y bitcóin entre las candidatas a palabra del año 2017 de la Fundéu (Noticia)
Una primera versión de esta recomendación se publicó el 27 de marzo del 2017.